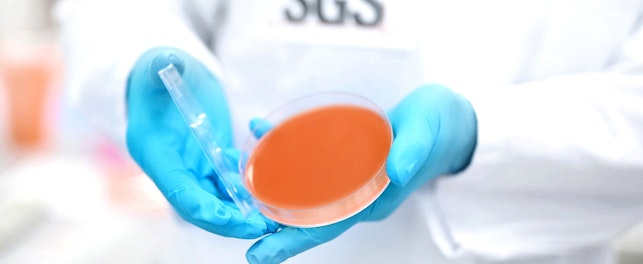
SGS Microbiology Services Lab Hamburg, Germany

Safety, efficacy and regulatory compliance in cosmetic products demand rigorous quality control (QC). Increasingly complex, this essential process requires specialized scientific knowledge, advanced instrumentation and deep regulatory insight. Many businesses lack the internal capacity to conduct the full spectrum of chemical, microbiological and stability testing required for efficient, compliant product development.
As regulatory scrutiny intensifies, outsourcing QC to a trusted provider offers a strategic advantage. It ensures access to cutting-edge expertise while delivering reliable results, operational agility and consistently market-ready products.
Financial benefits
Establishing and operating in-house laboratories is expensive, requiring significant investment in equipment, infrastructure, maintenance, staff training and ongoing regulatory surveillance. This can strain budgets and divert focus from core business activities.
Outsourcing offers a cost-effective alternative. By partnering with a trusted external provider, companies can reduce fixed costs, manage financial risk and reallocate internal resources more strategically.
This approach offers valuable flexibility. During periods of peak activity or unexpected demand, outsourced QC enables rapid scaling without the need to recruit, train and equip additional staff. It also supports one-off testing needs and helps businesses respond quickly to market shifts, regulatory updates and product development timelines, without compromising quality or compliance.
Access to advanced analytical capabilities
Outsourcing QC provides access to cutting-edge methods and specialist instrumentation that may be cost-prohibitive to maintain in-house, including:
- High-performance liquid chromatography (HPLC) for active ingredient analysis
- Gas chromatography coupled with mass spectrometry (GC-MS) for volatile impurities
- Microbiological analyses to verify the absence of contamination
- Stability studies to validate the shelf-life of products
- Specialized analyses, including:
- Heavy metals (lead, arsenic, mercury, cadmium)
- Per- and polyfluoroalkyl substances (PFAS) and other substances of concern
- Furocoumarins and regulated allergens
- Container-to-content testing to verify potential interactions between formula and packaging
Certified external laboratories also provide independent documentation that supports regulatory submissions and enhances traceability. This objectivity is trusted by standards bodies and consumers alike, reinforcing product credibility and brand integrity.
Examples of QC analyses:
- Microbiological analyses: hygiene control, conservation tests
- Regulatory analyses: heavy metals, allergens, ultraviolet (UV) filters, PFAS
- Stability studies: follow-up at 3, 6, 12 months to validate the durability of the product
- Container-content interaction: evaluation of migration risks and packaging/product compatibility
- Physico-chemical analyses: pH, viscosity, density, determination of active ingredients
SGS solutions
From raw materials to finished goods, our solutions support the entire life cycle of cosmetic products with end-to-end QC services tailored to international compliance requirements.
Backed by internationally accredited laboratories (ISO 17025, GLP), decades of sector expertise and a global network, we deliver fast, reliable testing designed to meet your operational needs.
Our modular QC services provide the flexibility to scale, respond to market shifts and manage peak demand without added infrastructure. We also offer proactive regulatory support that allows you to navigate evolving legislation and maintain compliance across global markets.
Key benefits:
- Accredited laboratories with global and local reach
- Flexible, scalable QC solutions
- Expert regulatory guidance
- Proven experience in cosmetic safety and compliance
Outsourcing QC to SGS gives you access to advanced methods, independent documentation and the agility to meet market demands.
For further information, please contact:
Jennifer Buckley
Senior Global Marketing Manager
Health & Nutrition
t: +1 973 461 1498